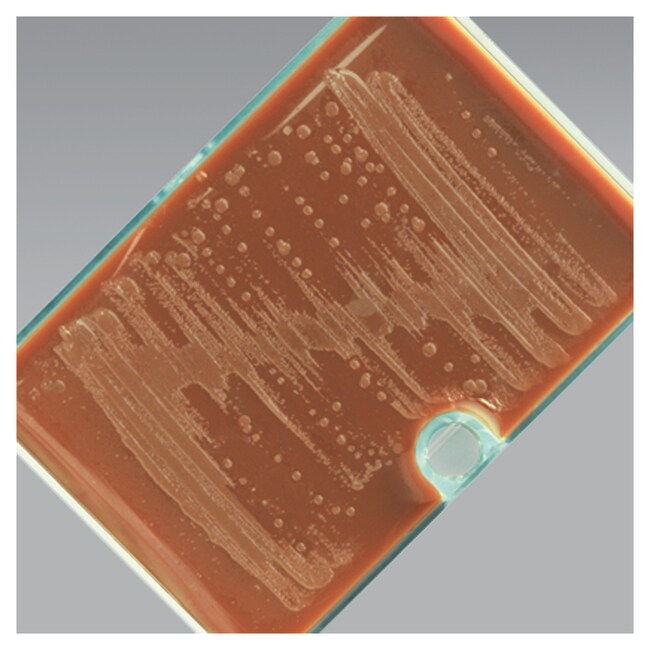
JEMBEC System with Thayer Martin Agar Improved (M-L) w/anisomycin, colistin, vancomycin, trimethoprim

Search
Search
Isolate Neisseria gonorrhoeae and Neisseria meningitidis using this medium.
| 货号 | dimFormat |
|---|---|
| R10320 |
Selectively isolate Neisseria gonorrhoeae and Neisseria meningitidis with Thermo Scientific™ Remel JEMBEC System with Thayer Martin Agar Improved (M-L) w/anisomycin, colistin, vancomycin and trimethoprim. Johnston introduced a medium to grow N. gonorrhoeae in 24 hours1 and this was the advent of GC Agar Base. Various studies have demonstrated improved recovery for pathogenic Neisseria spp. using selective media2-4. Martin and Lewis recommended the use of anisomycin, which is a more stable antifungal agent, to replace nystatin and increase the shelf life of the media5.
Thayer and Martin formulated a selective medium to isolate N. gonorrhoeae and N. meningitidis containing antibiotics capable of suppressing the commensal microbial flora present in the anal canal, vagina, pharynx, and other sites 6. The antibiotics used initially, ristocetin and polymyxin B, were replaced with vancomycin, colistimethate, and nystatin7. The medium contains an increased concentration of dextrose which allows better growth of gonococci.
Thayer and Martin Agar (Improved) contains hemoglobin, which provides the X factor (hemin), and GCHI Enrichment that provides the V factor, vitamins, amino acids, coenzymes, and dextrose. The tablet provided in the JEMBEC™ and Pill Pocket systems comes in contact with the water vapor present in the medium and liberates carbon dioxide into the enclosed pack.
Not all products are available for sale in all territories. Please inquire.
Remel™ and Oxoid™ products are now part of the Thermo Scientific brand.